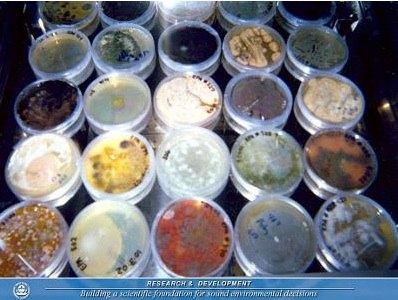
contrailscience.com_skitch_hygine_20120206_063313.jpg
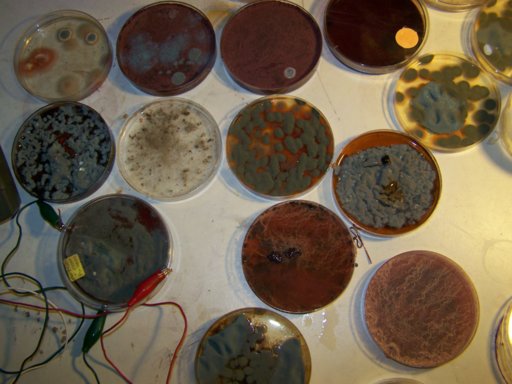
cultureexamples.jpg

he skirts this by trying to identify organic protein complexes and amino acids, mentioning a iron complex somewhere in there. he fails to mention that due to the absolute prevalence of microbial life on our planet these things are eeeeeeverywhere. his technique allows him to never have to actually identify anything explicitly.
Having done some work with edible fungus cultures myself i can attest to the hilarious PITA of sterile technique and from what i can see in the few shots you can see his 'lab' in, it doesn't look much more well equipped than mine has ever been. im sort of impressed to see a liquid chromatography column but that doesn't really say anything at all. ive seen MDMA cooks use them to produce a more pure product.
id also like to point out he does not seem to be working in a pos pressure environment or under a laminar flow hood at all times either... i see a power supply made of daisy chained 6v batteries.. all things i think are perfectly acceptable for a home lab, yet id never make such claims from my home lab(when i had it set up, ive since strayed a bit from my chem/bio hobby). i am still stuck on the arbitrary use of red wine as a culture medium. that screams incompetence on so many levels.

Edit: i also see canning jars being used, tupperware... things that are fine if you are making drugs or growing shitakes, but not okay if you are warping the minds of vulnerable people around the world.
I see he is holding his
post column purified protein extract in a canning jar while also using the jar lid... now i know for a FACT the metal/paint/rubber seals on those lids leach and are not even up the my standards, let alone that of biological research..... also note the jar is
outside a flow hood, with a camera held
above it post purification with nothing preventing debris from falling in..... incompetence. i wouldnt culture lions mane mushroom mycelium under these conditions.....
blah blah blah we cant all have infinite money and resources of the government blah blah. Ive managed. on $10 an hour with no donation buttons at that.....
and then i found this page...
http://www.carnicominstitute.org/articles/bio2011-4.htm

several(most) of these show multi point contamination, some even standard bread mold the top left shows a mold competing with a bacterium. you can tell by its ringed growth pattern and failure to cover the growth medium before sporulating and turning green/grey/blue....
"
An important observation is that, regardless of the variation in surface morphology, color or structure, the underlying spectral signature of the organism appears to be the same."
What the fuck!?! regardless of what you see in the images, a test that has nothing to do with mycology says they are the same... ookay..
with that ill be done.... i would however suggest he culture this thing of his, get a high res camera, and use it to make cool nebula/galaxy images because it sure looks cool and thats about all its worth.
edit: "it * doesn't* look much more well equipped"